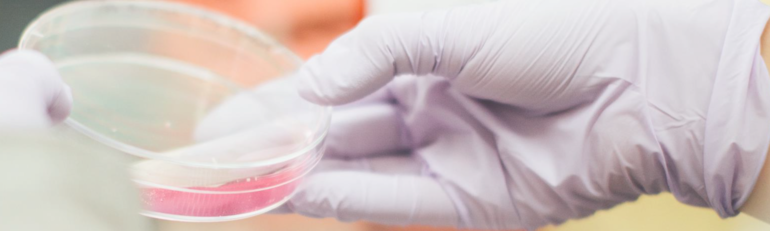

Geförderte Lebensmitteluntersuchungen 2025
Am Montag, den 06. Oktober 2025, können im Rahmen des Qualitätssicherungsprojekts Milch und Milchprodukte, Schmierwasserproben, Fisch, Fleisch und Fleischprodukte, Rauchbegleitstoffproben sowie Schlachtkörperproben in den Bezirkslandwirtschaftskammern abgegeben werden.
Jeder Lebensmittelunternehmer ist verantwortlich für die Sicherheit seiner Produkte. Bereits während der Herstellung werden Hygienemaßnahmen wie Reinigung und Erhitzung umgesetzt und umfassend dokumentiert (z.B. Reinigungs- und Desinfektionspläne, Temperaturaufzeichnungen). Ob diese Maßnahmen wirksam sind, lässt sich nur durch mikrobiologische und chemische Untersuchungen nachweisen. Besonders bei sensiblen Lebensmitteln wie Milch- und Fleischprodukten sind Untersuchungsparameter sowie deren Häufigkeit gesetzlich vorgeschrieben.
Grundsätzlich müssen das risikoreichste sowie das mengenmäßig am meisten produzierte Produkt eines Betriebes untersucht werden. Die erforderlichen Probenentnahmen werden anhand eines Probenplans in den Jahresablauf des Betriebs integriert – die Sammeltermine können dafür ideal genutzt werden.
Grundsätzlich müssen das risikoreichste sowie das mengenmäßig am meisten produzierte Produkt eines Betriebes untersucht werden. Die erforderlichen Probenentnahmen werden anhand eines Probenplans in den Jahresablauf des Betriebs integriert – die Sammeltermine können dafür ideal genutzt werden.
Förderung
Für Mitglieder des Landesverbands Tiroler-Direktvermarkter wird die Untersuchung der Lebensmittelproben (ausgenommen Alkoholgehalt) vom Land Tirol mit 80 % gefördert. Auch Trinkwasseruntersuchungen für Betriebe mit eigener Quelle sind förderbar bzw. solche,
die aufgrund einer Anordnung der Lebensmittelaufsicht erforderlich sind. Proben können ganzjährig in allen teilnehmenden Laboren abgegeben werden – jedoch nur nach vorheriger Anmeldung beim jeweiligen Labor.
Das Probenbegleitblatt Lebensmitteluntersuchungen bzw. bei Schlachtkörperuntersuchungen das Probenbegleitblatt Schlachtkörper muss sowohl für die eigenständige Abgabe der Proben, als auch für die Nutzung des Sammeltermins in der Bezirkslandwirtschaftskammer ausgefüllt werden. Die Unterlagen finden Sie im Downloadbereich.
Das Probenbegleitblatt Lebensmitteluntersuchungen bzw. bei Schlachtkörperuntersuchungen das Probenbegleitblatt Schlachtkörper muss sowohl für die eigenständige Abgabe der Proben, als auch für die Nutzung des Sammeltermins in der Bezirkslandwirtschaftskammer ausgefüllt werden. Die Unterlagen finden Sie im Downloadbereich.
Milch, Milchprodukte & Schmierwasser
Neben mikrobiologischen Untersuchungen können auch chemische Analysen durchgeführt werden. Diese dienen u. a. der korrekten Lebensmittelkennzeichnung (Bezeichnung des Lebensmittels), etwa durch die Bestimmung von:
- Fett- und Wassergehalt (zur Berechnung von F.i.T. und Wff-Gehalt)
- pH-Wert
- Alkalische Phosphatase (zur Kontrolle der Pasteurisierung)
Fleisch, Fleischprodukte, Schlachtkörperproben & Rauchbegleitstoffe
Besonders für die Schlachtkörperoberflächenproben ist eine termingebundene Abgabe der Proben schwierig. Deshalb besteht ganzjährig die Möglichkeit, Proben im akkreditierten Labor Food Hygiene Controll in Ötztal Bahnhof abzugeben – ebenfalls nur nach vorheriger Anmeldung.
Die für die Entnahme benötigten Materialien wie Skalpelle, Pinzetten, Schablonen, Stomacherbeutel, Styroporboxen oder Kratzschwämme für die Beprobung auf Salmonellen, können beim Fachbereich Spezialkulturen und Markt bestellt werden:
Kontakt:
Selina Halder
Tel.: +43 (0) 59292-1502
E-Mail: dvm@lk-tirol.at
Kontakt:
Selina Halder
Tel.: +43 (0) 59292-1502
E-Mail: dvm@lk-tirol.at
Förderzeitraum und Antragstellung
Mitglieder des Landesverbandes Tiroler-Direktvermarkter können für Untersuchungen zur Sicherung
der Lebensmittelqualität eine Förderung beantragen. Für 2025 beträgt der Fördersatz durch das Land
Tirol 80%. Auch Trinkwasseruntersuchungen für Betriebe mit eigener Quelle sind förderbar bzw. solche,
die aufgrund einer Anordnung der Lebensmittelaufsicht erforderlich sind.
Förderzeitraum und Antragstellung:
Der Zahlungsantrag muss bis spätestens 31.03.2026 für jene Rechnungen bzw. Untersuchungen gestellt werden, die den Zeitraum von 01.01.2025 bis 31.12.2025 betreffen.
Wichtige Hinweise:
Förderzeitraum und Antragstellung:
Der Zahlungsantrag muss bis spätestens 31.03.2026 für jene Rechnungen bzw. Untersuchungen gestellt werden, die den Zeitraum von 01.01.2025 bis 31.12.2025 betreffen.
Wichtige Hinweise:
- Der Zahlungsantrag kann nur einmal für das Jahr 2025 gestellt werden. Bitte achten Sie da her darauf, dass alle Untersuchungen positiv abgeschlossen und vollständig abgerechnet sind.
- Die Auszahlung der Förderung erfolgt erst, nachdem alle Zahlungsanträge bearbeitet wurden. Der voraussichtliche Auszahlungstermin durch das Land Tirol ist Anfang Juli 2026
Ansprechpersonen im Bezirk:
| Bezirk Imst: | Angelika Wachter | Tel.: 05 92 92-2102 | angelika.wachter@lk-tirol.at |
| Bezirk Innsbruck: | Michelle Auer | Tel.: 05 92 92-2207 | michelle.auer@lk-tirol.at |
| Bezirk Kufstein: | Andreas Gwiggner | Tel.: 05 92 92-2402 | andreas.gwiggner@lk-tirol.at |
| Bezirk Kitzbühel: | Katharina Horngacher | Tel.: 05 92 92-2302 | katharina.horngacher@lk-tirol.at |
| Bezirk Landeck: | Alina Kössler | Tel.: 05 92 92-2500 | alina.koessler@lk-tirol.at |
| Bezirk Lienz: | Natalie Kollnig | Tel.: 05 92 92-2604 | natalie.kollnig@lk-tirol.at |
| Bezirk Reutte: | Sarah Klages | Tel.: 05 92 92-2703 | sarah.klages@lk-tirol.at |
| Bezirk Schwaz: | Bernadette Eberl | Tel.: 05 92 92-2805 | bernadette.eberl@lk-tirol.at |